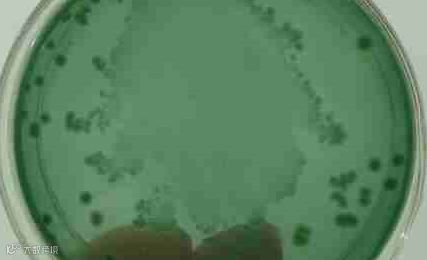

陈老板,佛罗,求雨村;3.5亩水面,1.4米水深

一个星期前经过检测发现绿弧菌严重超标,黄弧菌也有少量几颗
通过微信交流,建议他使用弧光(2亩/瓶),由于使用时水面悬浮物较多,所以先用底毒消(2亩/瓶),然后再使弧光,陈总对待工作非常认真,使用产品以后也进行了检测,尽发现培养基上绿弧菌几乎没有了,只有几个绿弧菌,他很满意,也及时跟我分享了产品使用的效果











 正洋生物
正洋生物陈老板,佛罗,求雨村;3.5亩水面,1.4米水深
一个星期前经过检测发现绿弧菌严重超标,黄弧菌也有少量几颗
通过微信交流,建议他使用弧光(2亩/瓶),由于使用时水面悬浮物较多,所以先用底毒消(2亩/瓶),然后再使弧光,陈总对待工作非常认真,使用产品以后也进行了检测,尽发现培养基上绿弧菌几乎没有了,只有几个绿弧菌,他很满意,也及时跟我分享了产品使用的效果












